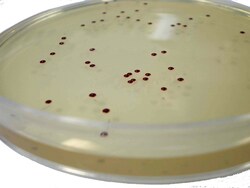
Scharlab Slanetz Bartley Agar Base Slanetz Bartley Agar Base; Form: Fast | Buy Online | Scharlab | Fisher Scientific

missing translation for 'onlineSavingsMsg'
Läs mer
Läs mer
Scharlab Slanetz Bartley Agar Base
Klicka för att se tillgängliga alternativ
:
Slanetz Bartley Agar Base; Form: Fast
Beskrivning
- ISO
- Differentialselektivt medium för detektion och räkning av enterokocker enl ISO 7899-2 standard.
- Detta medium måste tillsätta 1% TTC steril lösning (Art.nr:06-023).
- Det beredda mediet (Art.nr:064PF6017P) som inte innehåller tillsatsen TTC 1%.
Specifikationer
Specifikationer
| Certifikat och efterlevnad | ISO 7899-2 |
| Form | Solid |
| Medietyp | Slanetz Bartley Agar Base |
| Produkttyp | Differentialselektivt medium |
| Målorganismklass | Gram-positiva Cocci |
| Formulering | Tryptos 20,0 g/L, Jästextrakt 5,0 g/L, Dextros 2,0 g/L, Dikaliumfosfat 4,0 g/L, Natriumazid 0,4 g/L, Agar 12,0 g/L |
| För användning med (applikation) | Detektion och uppräkning av enterokocker |
| Inkubationsförhållanden | 36 °C± 2,0 °C |
| Inkubationstid | 44± 4 timmar. |
| pH | 7.2± 0,1 |
| Visa mer |
Korrigering av produktinnehåll
Din input är viktig för oss. Fyll i det här formuläret för att ge feedback relaterad till innehållet på denna produkt.
Produkttitel
Hittar du en möjlighet till förbättring?Dela en innehållskorrigering